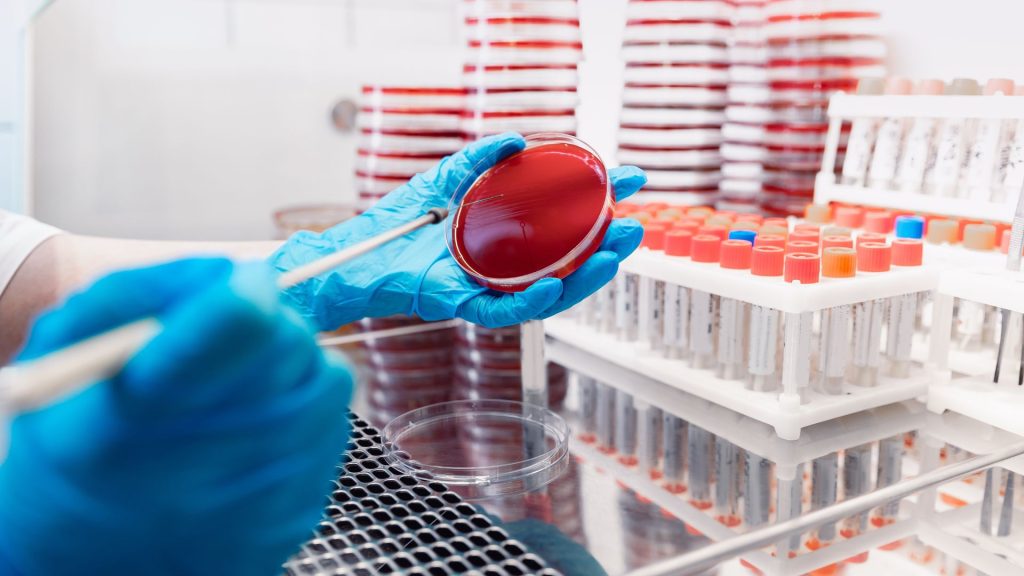

Laboratorio de microbiología: Auditorias regulatorias Nacionales e Internacionales
ARANCEL NO SOCIOS: AR$ 466.000
MODALIDAD
INICIO
FINALIZACIÓN
CARGA HORARIA
ENCUENTROS
CAT: Cursos Regulares -
CÓD: 1105 -
CEx: MICROBIOLOGÍA
DÍAS Y HORARIOS
Lunes 3 y 10 de Noviembre 18 a 21 hs.
OBJETIVOS
Crear un espacio donde podamos compartir y disertar sobre todo lo relacionado con auditorías externas, trabajando no desde la normativa de manera estricta, sino a partir de las experiencias pasadas. La idea es generar un lugar de debate e intercambio para construir, entre todos, un compendio de requerimientos que no se encuentran claramente establecidos en la normativa, pero que, al momento de ser auditados, debemos cumplir.
DIRIGIDO A
Técnicos y profesionales de las áreas de Aseguramiento de la Calidad, Control de Calidad, Ingeniería, Producción u otras áreas de la Industria Farmacéutica, Cosmética, Veterinaria o de Productos Médicos. También incluye a estudiantes avanzados de carreras afines a la Industria Farmacéutica que se encuentren trabajando en ella, así como a todas aquellas personas interesadas en profundizar sus conocimientos en las áreas de incumbencia.
EMISIÓN DE CERTIFICADO
COORDINACIÓN:
Stella Maris Stagnaro
DISERTANTES:
- Lic. en Ciencias Biológicas, Universidad CAECE. Farmacéutico, Universidad Argentina John F. Kennedy.
- Curso de posgrado en Biología Molecular Aplicada a la Microbiología Clínica – Inst. Universitario Italiano de Rosario
- Posgrado de Especialización en Control de Calidad Industrial – Quality Management – INCALIN (INTI – Universidad Nacional San Martin).
- Certificación: Gestión de la Calidad y Competencia Técnica en Laboratorios de Calibración y Ensayos ISO/IEC 17025:2005.PTB (ALEMANIA); INTI; UNSAM – Universidad Nacional de San Martin.
Bioquímica de grado con un Máster en Tecnología de los Alimentos realizado en la de la Universidad de Buenos Aires (UBA) y un Máster of Business and Management en la Universidad de WAIKATO, Nueva Zelanda.
Se desarrollo profesionalmente en laboratorios Nacionales y Multinacionales en las áreas de Control de Calidad fisicoquímico y microbiología. Además tiene experiencia en Inmunología clínica y consultoría profesional.
Martin es Farmacéutico, de la Facultad de Farmacia y Bioquímica de la UBA, egresando en el año 2003. Además, se especializó en 2009, en Dirección de Operaciones farmacéuticas.
Su carrera laboral se inició en Ingeniería Ambiental, pero desde hace más de 20 años se dedica a la industria farmacéutica. Ha trabajado en la ANMAT, dependiente del Ministerio de Salud de la Nación, y en varias empresas farmacéuticas del sector privado. Actualmente es DT de un laboratorio, y director asociado de una consultora que brinda soporte a otras compañías del sector. Es integrante del comité de expertos y comisión directiva de la Sociedad Argentina de Farmacia y Bioquímica industrial, y profesor adjunto del posgrado de “Quality Assurance” de la UCES.
Farmacéutica de la Universidad Argentina John F. Kennedy desde el año 2016
Diplomada en farmacia industrial de la Asociación de Farmacia y Bioquímica Industrial (SAFYBI).
Además es Técnica superior en biotecnología y análisis químico-biológico, de la Escuela Técnica ORT, 2003.
Actualmente se desempeña como Supervisora del laboratorio de Microbiología del Instituto Massone y es integrante del Comité de Expertos en Microbiología de SAFYBI.
Farmacéutica y Licenciada en Ciencias Farmacéuticas de la Universidad Nacional de La Plata (UNLP). Actualmente se desempeña como jefa de Microbiología de Planta La Plata, de Laboratorios Bagó, y posee experiencia en Productos médicos y cosméticos.
Es integrante activa de la Sub comisión de Microbiología de la Farmacopea Nacional Argentina.
TEMARIO
- Buenas Prácticas de fabricación en el laboratorio de Microbiología: Medios de
cultivo, cultivos microbiológicos, Identificación, Equipos, Muestras. - Sistemas críticos de soporte: agua y sistemas de aire, otros.
- Comportamientos y conductas durante las Auditorías e inspecciones.
- Experiencias de auditorías: recomendaciones, observaciones.
INVIERTE EN TU FORMACIÓN
SOCIOS ACTIVOS / ADHERENTES 100% OFF | AR$ 0 |
ESTUDIANTES NO SOCIOS | AR$ 233.000 |
NO SOCIOS | AR$ 466.000 |
Al ser SOCIO SAFYBI obtienes bonificaciones desde 50% a 100% en nuestras Diplomaturas, Cursos y Actividades.
Y muchos Beneficios más. ¿Todavía no te asociaste?
FORMAS DE PAGO
TRANSFERENCIA BANCARIA

¡Podés pagar en cuotas con tu tarjeta de crédito!

ECHEQS
Lee atentamente los términos y condiciones de nuestras actividades antes de completar el formulario de inscripción.
